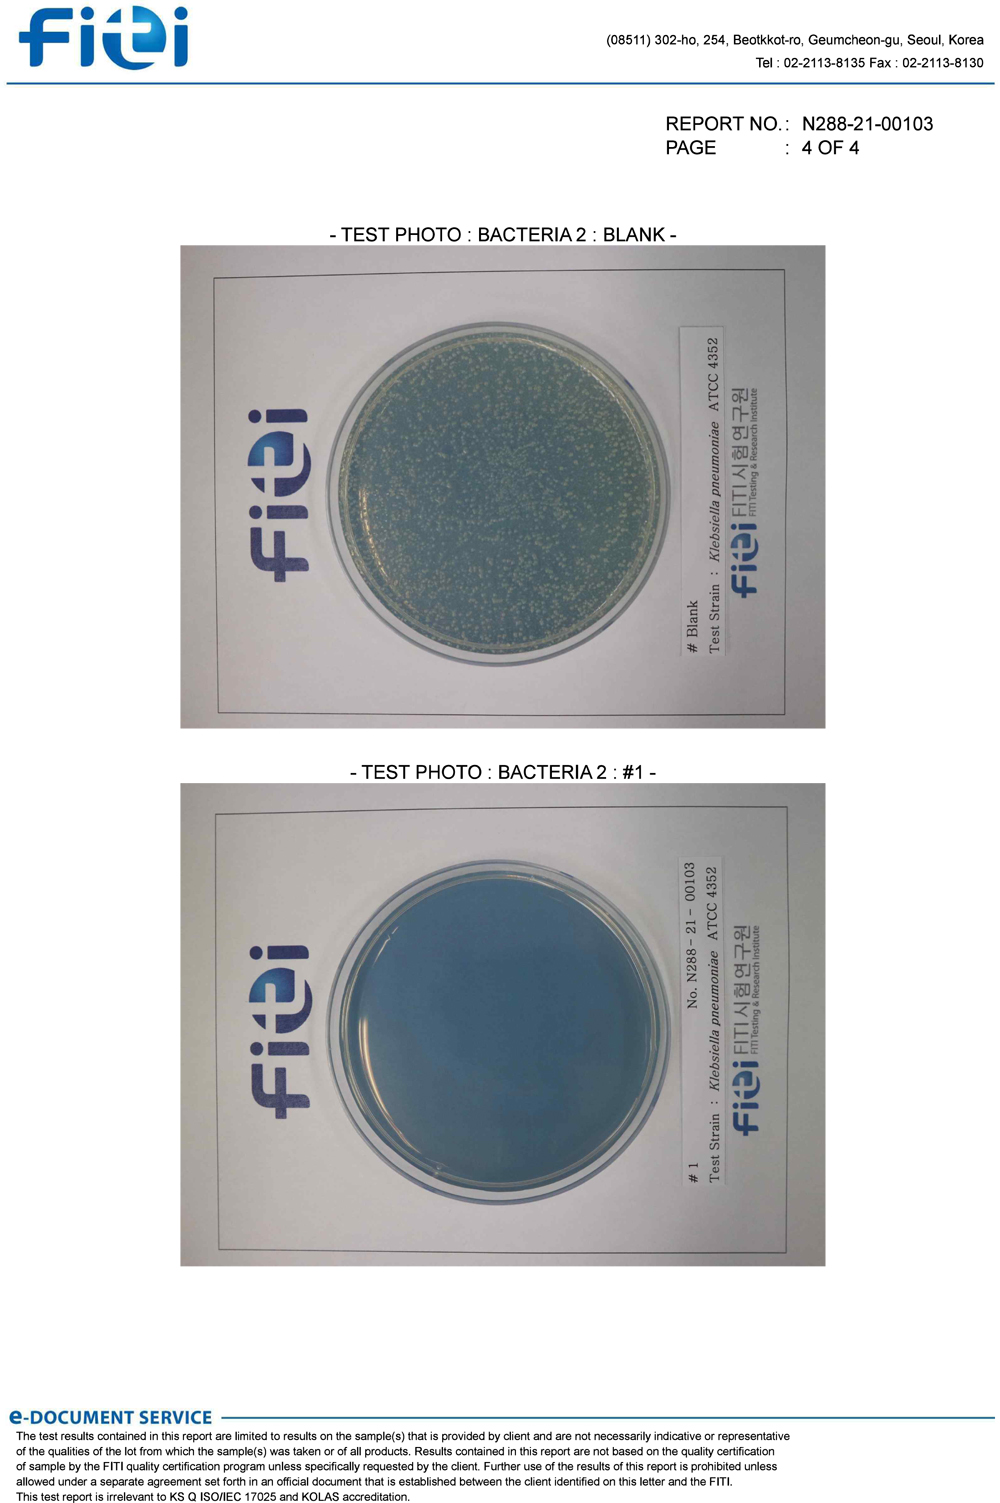

항균시험 성적서
페이지 정보

본문

FBZ 은나노 항균시험 성적서
첨부파일
-
copy-1616387796-FITI_FBZ20EC9D80EB8298EB85B820ED95ADEAB7A020EC8B9CED979820N2882100103_1-1.pdf (337.6K)
40회 다운로드 | DATE : 2022-07-14 17:39:33
- 이전글Carcare Towel Catalogue(CAR CARE SYSTEM)_2021 Version 24.09.09
- 다음글키친타월 카탈로그(Premium Kitchen Towel) 22.07.14
